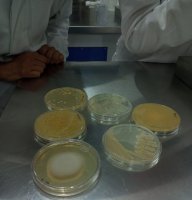

Guanajuato, Gto., a 19 de junio de 2025.- El Colegio del Nivel Medio Superior (CNMS) de la Universidad de Guanajuato (UG) organizó el curso de actualización “Estrategias Didácticas de Biología Aplicada” con el propósito de fortalecer la formación docente en el Nivel Medio Superior (NMS).
Esta iniciativa se conjunta desde la Coordinación de Programas Educativos y Personal Académico de la Dirección del CNMS en colaboración con la Dra. Claudia Erika Morales Hernández, profesora de la Escuela de Nivel Medio Superior (ENMS) de Guanajuato, y autoridades del Departamento de Biología del Campus Guanajuato.
Esta capacitación, dirigida al profesorado que imparte las Unidades de Aprendizaje (UDAs) "Introducción a la Microbiología" y "Biología I", tuvo como objetivos principales brindar herramientas prácticas para la enseñanza colaborativa de la Biología, además de fortalecer el vínculo académico entre los niveles medio superior y superior en esta área del conocimiento. La actividad se llevó a cabo los días 16, 17 y 18 de junio en los laboratorios del Departamento de Biología.
En total, participaron 35 docentes provenientes de las ENMS Guanajuato, Salvatierra, Silao, Salamanca, Irapuato, Celaya, Moroleón y Pénjamo.
Las sesiones fueron impartidas por un destacado equipo académico del Departamento de Biología de la División de Ciencias Naturales y Exactas del Campus Guanajuato, conformado por la M.C. Juana López Godínez, la Dra. Juana Elizabeth Reyes Martínez, el Dr. Julio César Villagómez, el QFB. Luis Rafael Cardoso Reyes y el M.C. Aurelio Álvarez Vargas.
Con estos cursos, se impulsa la calidad educativa y la profesionalización continua de la planta docente.